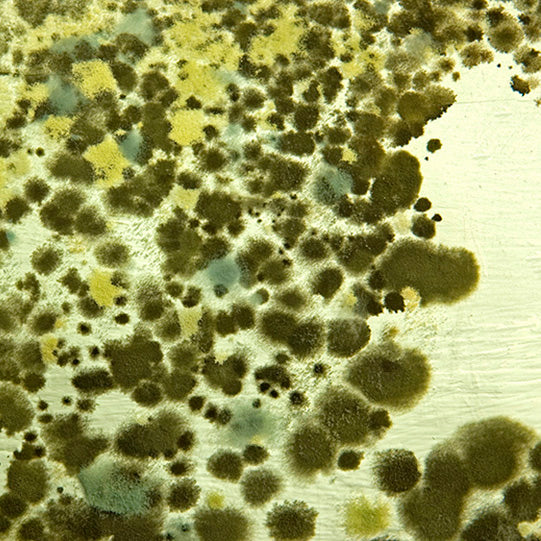

-

Household Cleaners
Our sustainable household cleaners are the best on the market. Use them for routine cleaning, or for emergencies like when the milk boils over.
-

Floor Cleaners
If the floor is clean, it adds immense orderliness and coherence to your whole house. Our floor cleaners are a delight to use; they're non-toxic, highly effective and economical.
-

Mold & Mildew
Getting rid of mold and mildew is a nasty job so the cleaner better be right! We also offer a mold test kit to identify what type of mold you're dealing with.
Multi-Purpose Cleaner and Degreaser, 1-Quart
Save: $1.65
Marmoleum Neutral pH Cleaner, 1-Quart
Save: $2.34
Blissfully Clean, 500g, Unscented, Green Cloth
Save: $2.99
Concentrate, 1-Quart
Save: $2.07
Grout Smart, 1-Quart
Save: $1.29
Carpet Shampoo, 1-Quart
Save: $2.36
PerfectCLEAN Cloth, Gray - 5-Pack
Save: $1.49
Save: $1.49
Hardwood Floor Cleaner, Concentrate, 1-Quart
Save: $1.42
Power Safe, 1-Quart
Cleaning Wipes, Small Tub
Save: $1.90
Floor Soap, 33.8-Fl Oz (1-Liter)
Save: $2.08
Mineral X, 1-Quart
Save: $1.21
Surface Care Spray for Oiled Floors, 750ml
Save: $2.15
Save: $2.15
Glass Smart, 1-Quart
Carpet Cleaning Polymer, 1-Quart
Save: $2.18
Detergente Neutro Hardwood Floor Cleaner
Save: $9.97
WoolClean Spot Removal Kit
600GL Coatings Remover, 1-Quart
500MR Mastic Remover, 1-Gallon
Citrus Thinner, 25-Fl Oz (0.75-Liter)
700DG Degreaser, 1-quart (formerly Emerge)
Rubio Exterior Wood Cleaner, 100-Milliliter
Industrial Strength Concrete Cleaner, 1-Gallon
Pro Series - Hardwood Floor Cleaner, 1-Quart
Cleaners
Our cleaners are non-toxic and pleasant to use. Plus, they work well. Like all our products, they've been well researched and tested.